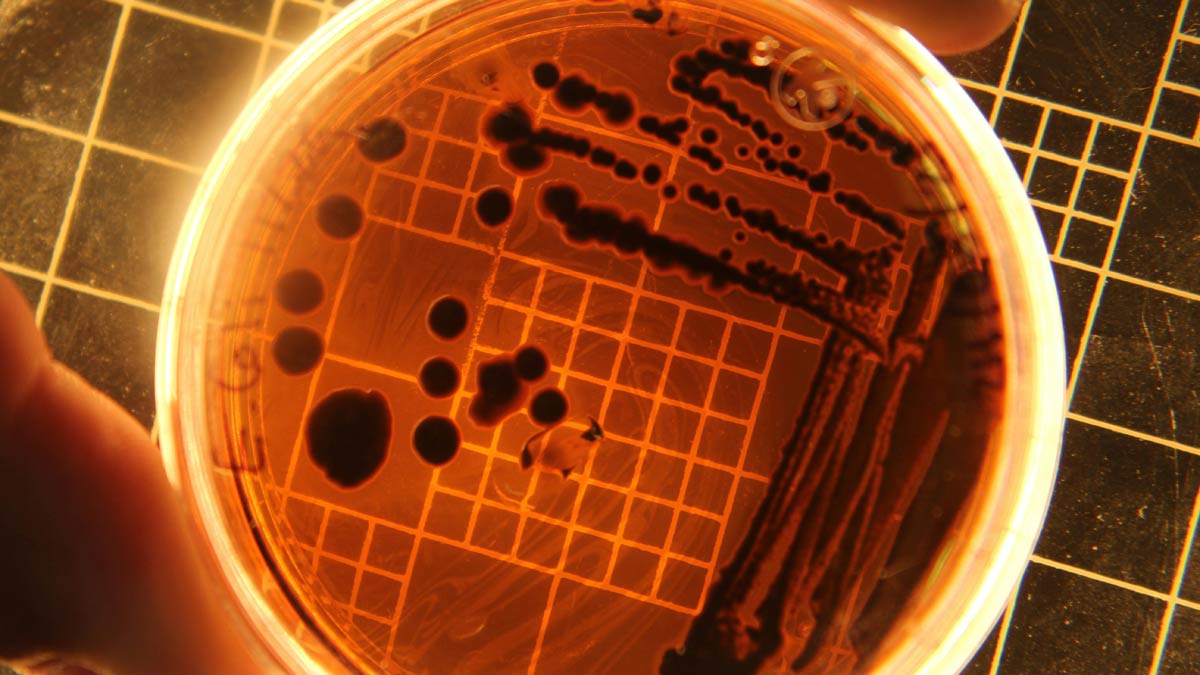

מגה מזון
חדשות
חדשות ריקול
ריקול: סלמונלה בטחינת הנסיך
10/12/2025
זמן קריאה: 0.5 דק'
חברת טחינת הנסיך מבקשת ליידע כי בחלק ממוצריה התקבלה תוצאה חיובית לסלמונלה. בתיאום עם שירות המזון ומתוך אמצעי זהירות ואחריות כלפי לקוחותיה, מבוצעת החזרה יזומה של מוצרי טחינה גולמית מכל תאריכי התפוגה מ־13/7/2027 עד 6/11/2027, כולל.
המוצרים:
- אל אמיר 450 גרם + אל אמיר 900 גרם + 17 ק"ג.
- טעמן 450 גרם - טהורה ומלאה.
- רמי לוי 500 גרם - טהורה ומלאה.
- רמי לוי 1 ק"ג טהור.
- הנסיך טהור 450 גרם + הנסיך טהור 17 ק"ג.
- הנסיך מלאה 450 גרם.
- KAPRI 450 גרם + ו־KAPRI 900 גרם.
- גרגיר הזהב 500 גרם.
החברה מבקשת ממי שרכשו את מוצרי החברה מהתאריכים הנ"ל להימנע מצריכתם.
במידת הצורך אפשר להתקשר למוקד שירות הצרכנים בטלפון:04-6780301.
באנשים בריאים, חיידק הסלמונלה עלול לגרום למחלת מעיים המתבטאת בחום, שלשול, בחילה, הקאות וכאבי בטן. במקרים נדירים עלולים להיגרם סיבוכים. באוכלוסיות רגישות כגון ילדים צעירים, בעלי מערכת חיסון מוחלשת וקשישים, החיידק עלול לגרום מחלה קשה ואף מוות.
אילוסטרציה
תגובות